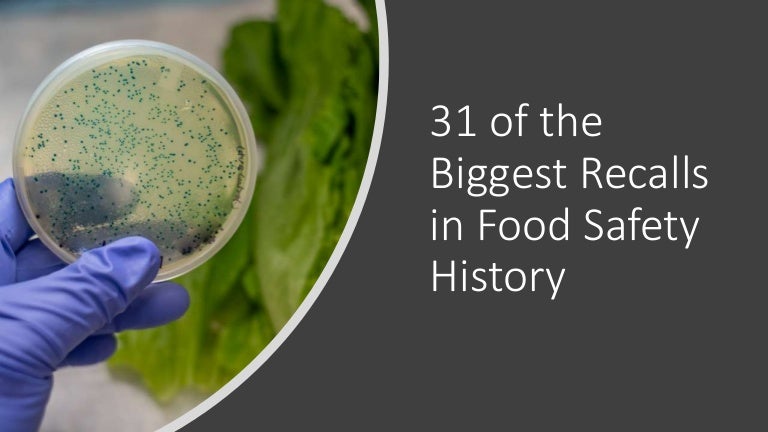
31 Of The Biggest Recalls In Food Safety History -

E Coli O157h7 And Hus Outbreak Investigation Implicates
E Coli O157h7 And Hus Outbreak Investigation Implicates

 Escherichia Coli Wikipedia
Escherichia Coli Wikipedia
 Pdf Lessons From A Large Outbreak Of Escherichia Coli O157
Pdf Lessons From A Large Outbreak Of Escherichia Coli O157
 E Coli O157 H7 Abebooks
E Coli O157 H7 Abebooks
 Ecoli O157h7 Infections And Hus The Missing Link Food
Ecoli O157h7 Infections And Hus The Missing Link Food
31 Of The Biggest Recalls In Food Safety History
31 Of The Biggest Recalls In Food Safety History
 Pdf Protozoan Predation Of Escherichia Coli O157h7 Is
Pdf Protozoan Predation Of Escherichia Coli O157h7 Is
 Can I Sue A School For E Coli Food Poisoning On Behalf Of
Can I Sue A School For E Coli Food Poisoning On Behalf Of
 Is It Reckless Misconduct To Grow Process And Sell
Is It Reckless Misconduct To Grow Process And Sell
 The Reality Of An E Coli Outbreak Marler Blog
The Reality Of An E Coli Outbreak Marler Blog
 German E Coli Infections Leap To 1534 Cbc News
German E Coli Infections Leap To 1534 Cbc News
 Food Poisoning Lawyers And Attorneys Marler Clark
Food Poisoning Lawyers And Attorneys Marler Clark
Escherichia Coli
Escherichia Coli
 Hus Barfblog
Hus Barfblog
 The Natural History Of Model Organisms The Unexhausted
The Natural History Of Model Organisms The Unexhausted

